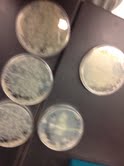

Uploads by Brady S. Laughlin
From OpenWetWare
Jump to navigationJump to search
This special page shows all uploaded files.
| Date | Name | Thumbnail | Size | Description |
|---|---|---|---|---|
| 03:19, 26 October 2013 | Kah126gel.jpg (file) | 93 KB | ||
| 21:29, 20 October 2013 | Supercali.jpg (file) | 408 KB | ||
| 04:06, 12 October 2013 | Whyohwhy.jpg (file) | 84 KB | ||
| 04:01, 12 October 2013 | Abc12.jpg (file) | 110 KB | ||
| 21:52, 7 October 2013 | Ihavenoideawhyitsnotworking.jpg (file) | 81 KB | ||
| 20:44, 28 September 2013 | Chickennoodlesoupwithsodaonside.jpg (file) | 132 KB | ||
| 07:07, 27 September 2013 | Hiddendragonsofthetemple.jpg (file) | 160 KB | ||
| 01:32, 27 September 2013 | Noresults.jpg (file) | 2.09 MB | ||
| 03:20, 14 September 2013 | Cmvgel2.jpg (file) | 92 KB | ||
| 03:13, 14 September 2013 | Cmvgel1 cutout.jpg (file) | 111 KB | ||
| 03:09, 14 September 2013 | Cmvgel1.jpg (file) | 102 KB | ||
| 03:30, 8 September 2013 | Cmv.jpg (file) | 1.96 MB | ||
| 03:25, 8 September 2013 | CMV promoter9-6-2013.jpg (file) | 203 KB | ||
| 00:46, 29 July 2013 | Brady1 lab.jpg (file) | 147 KB | ||
| 07:05, 23 April 2013 | Plates4 22 2013.jpg (file) | 286 KB | ||
| 18:08, 2 April 2013 | Plates4 2 2013.jpg (file) | 263 KB | ||
| 17:58, 2 April 2013 | Plates3 27 2013.jpg (file) | 257 KB | ||
| 20:47, 26 March 2013 | Gel3 25 2013 cutout.jpg (file) | ![]() |
44 KB | |
| 20:42, 26 March 2013 | Gel3 25 2013.jpg (file) | ![]() |
62 KB | |
| 03:20, 23 March 2013 | Gel3 22 2013 cutout.jpg (file) | 73 KB | ||
| 03:15, 23 March 2013 | Gel3 22 2013.jpg (file) | 153 KB | ||
| 03:09, 6 March 2013 | Gel3 5 2013 cutout.jpg (file) | 96 KB | ||
| 03:04, 6 March 2013 | Gel3 5 2013.jpg (file) | 126 KB | ||
| 05:46, 4 March 2013 | Plates 3 3 2013.jpg (file) | 89 KB | ||
| 23:40, 14 February 2013 | Gg gel2-9-2013.jpg (file) | 15 KB | ||
| 20:14, 9 February 2013 | Plates 1 8 2013.jpg (file) | 1.98 MB | ||
| 20:09, 9 February 2013 | Plates 1 5 2013.jpg (file) | 2.27 MB | ||
| 05:42, 28 January 2013 | Hayneslab2.jpeg (file) | 7 KB | ||
| 05:26, 28 January 2013 | Gg gel1-25-2013.jpg (file) | 139 KB | ||
| 08:36, 14 December 2012 | December 12 2012plateread.jpg (file) | 269 KB | ||
| 08:21, 14 December 2012 | December 12 2012.jpg (file) | 229 KB | ||
| 22:58, 7 December 2012 | Pcrsett.jpg (file) | 1.7 MB | ||
| 04:21, 7 December 2012 | December 6 2012.jpg (file) | 165 KB | ||
| 20:16, 21 October 2012 | October 16 gel.jpg (file) | 2.86 MB | ||
| 16:53, 3 October 2012 | October 2 gel.jpg (file) | 420 KB | ||
| 19:44, 12 September 2012 | Zyppy.jpg (file) | 382 KB | ||
| 01:31, 8 September 2012 | Pseptemberresults3.jpg (file) | 1.79 MB | ||
| 01:31, 8 September 2012 | Pseptemberresults2.jpg (file) | 2.05 MB | ||
| 01:30, 8 September 2012 | Septemberresults1.jpg (file) | ![]() |
4 KB | |
| 01:27, 8 September 2012 | Brady lab.jpg (file) | 254 KB | ||
| 18:19, 25 August 2012 | Progress2.jpg (file) | 113 KB | ||
| 18:15, 25 August 2012 | Progress.jpg (file) | 24 KB | ||
| 19:15, 17 April 2012 | FlyPCDresults.jpg (file) | 306 KB | ||
| 04:03, 13 April 2012 | HAYNESLAB3.jpeg (file) | 46 KB | ||
| 23:44, 6 April 2012 | Flyligation01.jpg (file) | 1.93 MB | ||
| 03:27, 22 March 2012 | FshPCDresults01.jpg (file) | 289 KB | ||
| 05:37, 13 March 2012 | Group1assembly001.jpg (file) | 42 KB | ||
| 05:33, 13 March 2012 | Group1assembly01.jpg (file) | 32 KB | ||
| 01:54, 13 March 2012 | Group1assembly02.jpg (file) | 15 KB | ||
| 01:52, 13 March 2012 | Group1assembly2.jpg (file) | 15 KB |